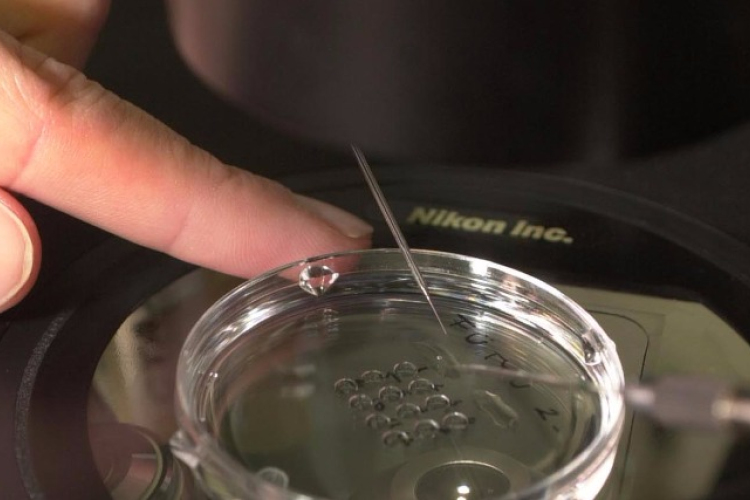
Nem mindig a nő tehet róla

Hírek
2016. Február 24. 09:49, szerda | Helyi
Nem mindig a nő tehet róla
Általában fel sem merül, hogy a férfi miatt marad el a gyermekáldás, holott a nőknél ma már jóval több a meddő férfi. Minden ötödik pár küzd a gyerekért.

2015. Augusztus 22. 09:00, szombat | Helyi
A stressz megbetegíti a születendő babát
Ha a kismamát terhessége alatt mindennapos stressz éri, később a gyermeknél egészségügyi problémák jelentkezhetnek, például légúti-, bőr- vagy emésztőrendszeri megbetegedések fordulhatnak elő a kicsinél.

2015. Április 26. 19:00, vasárnap | Életmód
STRIÁK – (Mit) tehetsz ellenük?
A tavaszi, nyári időszak gátlástalan megkeserítői (a narancsbőr mellett) a striák, vagy más néven terhességi csíkok. Születésük valójában az élet rendje (babavárás), ám néha mi is tehetünk róla.

2015. Március 22. 13:00, vasárnap | Életmód
Miért nézik a férfiak a nők fenekét?
A kőkor befolyásolja még mindig a férfiakat, akik a "homokóra alakú" nőket keresik - állapította meg egy tudományos tanulmány. És valójában nem is a nők feneke érdekes, hanem a gerincük hajlásszöge!

2015. Február 16. 10:02, hétfő | Életmód
Kávék, gyógyteák és más szerek a terhesség alatt
A várandósság különleges állapot, amelyben az anyának fokozottan oda kell figyelnie arra, hogy mit eszik és iszik, hiszen mindez befolyással lehet a magzat fejlődésére.

2014. Augusztus 03. 05:00, vasárnap | Életmód
Mennyit igyanak a kismamák?
A folyadékpótlás szempontjából is megkülönböztetett figyelmet érdemelnek a kismamák.

2014. Április 26. 06:00, szombat | Belföld
Ha kiderül a terhességem, kirúgnak! – Kirúghatnak? – jogos kérdés
Próbaidővel dolgozó kismama kereste meg az onlinejogszebesz.hu szakérőit, azzal a kérdéssel, hogy kirúghatják-e, ha rájönnek, hogy terhes. Vagy menjen veszélyeztetett terhesként táppénzre? Ne feledje, joga van kérdezni!
2012. Május 25. 07:11, péntek | Belföld
A túlsúlyos kismamáknak nagyobb gyerekük lesz
A terhesség előtt és alatt túlsúlyos nőknek nagyobb az esélyük arra, hogy születendő csemetéjük is nagy súllyal jöjjön a világra - írja a Health Day.
2012. Május 19. 14:01, szombat | Belföld
Itthon is engedélyezik az abortusztablettát
Megkapta a magyarországi forgalomba hozatali engedélyt az abortusztabletta – értesült a Magyar Nemzet.
2012. Április 17. 07:01, kedd | Belföld
A kismamák is nyugodtan kávézhatnak
Nem okoz alvászavart a babáknál, hogyha mamájuk terhesség vagy szoptatás alatt naponta fogyasztott kávét – mutatott rá egy brazil tanulmány, amelynek keretében kilencszáz kismamát és babájukat vizsgálták meg.
2012. Február 06. 13:55, hétfő | Belföld
A cukorbetegség tehet mindenről?
Négyszeresére emelkedik a veleszületett rendellenességek kockázata, ha az állapotos nőnek diabétesze van – idézte brit kutatók megállapítását a BBC hírportálja.
2011. Október 17. 07:45, hétfő | Belföld
Egyre komolyabban veszik a fiatalok a biztonságos szexet
Egy friss amerikai felmérés szerint a tizenéves fiúk egyre komolyabban veszik a biztonságos szexet, egyre többen használnak ugyanis óvszert az első együttlét során.
2011. Október 04. 07:41, kedd | Belföld
Évi 8 millió abortuszt hajtanak végre Kínában
Évi nyolc millió abortuszt hajtanak végre Kínában egy friss felmérés szerint, ráadásul a beavatkozáson átesett nők fele nem először választja a terhesség megszakítást.
